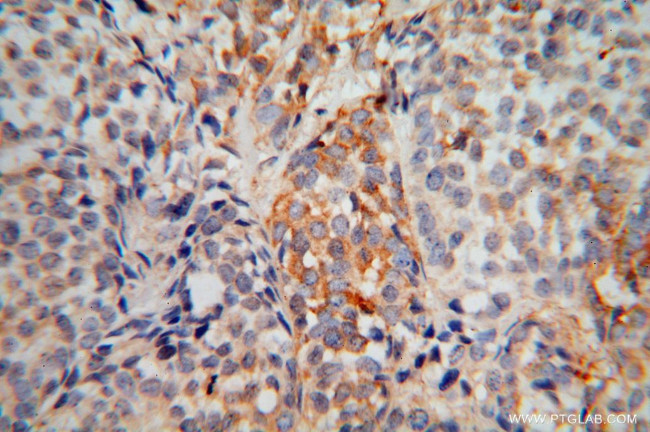
EXOSC5 Antibody in Immunohistochemistry (Paraffin) (IHC (P))

Search
Proteintech
EXOSC5 Polyclonal Antibody
{{$productOrderCtrl.translations['antibody.pdp.commerceCard.promotion.promotions']}}
{{$productOrderCtrl.translations['antibody.pdp.commerceCard.promotion.viewpromo']}}
{{$productOrderCtrl.translations['antibody.pdp.commerceCard.promotion.promocode']}}: {{promo.promoCode}} {{promo.promoTitle}} {{promo.promoDescription}}. {{$productOrderCtrl.translations['antibody.pdp.commerceCard.promotion.learnmore']}}
Product Details
15627-1-AP
Species Reactivity
Host/Isotype
Class
Type
Immunogen
Conjugate
Form
Concentration
Amount
Purification
Storage buffer
Contains
Storage conditions
Shipping conditions
Product Specific Information
Immunogen sequence: MEEEMHTDA KIRAENGTGS SPRGPGCSLR HFACEQNLLS RPDGSASFLQ GDTSVLAGVY GPAEVKVSKE IFNKATLEVI LRPKIGLPGV AEKSRERLIR NTCEAVVLGT LHPRTSITVV LQVVSDAGSL LACCLNAACM ALVDAGVPMR ALFCGVACAL DSDGTLVLDP TSKQEKEARA VLTFALDSVE RKLLMSSTKG LYSDTELQQC LAAAQAASQH VFRFYRESLQ RRYSKS (1-235 aa encoded by B C007742)
Target Information
Non-catalytic component of the RNA exosome complex which has 3'->5' exoribonuclease activity and participates in a multitude of cellular RNA processing and degradation events. In the nucleus, the RNA exosome complex is involved in proper maturation of stable RNA species such as rRNA, snRNA and snoRNA, in the elimination of RNA processing by-products and non-coding 'pervasive' transcripts, such as antisense RNA species and promoter-upstream transcripts (PROMPTs), and of mRNAs with processing defects, thereby limiting or excluding their export to the cytoplasm. The RNA exosome may be involved in Ig class switch recombination (CSR) and/or Ig variable region somatic hypermutation (SHM) by targeting AICDA deamination activity to transcribed dsDNA substrates. In the cytoplasm, the RNA exosome complex is involved in general mRNA turnover and specifically degrades inherently unstable mRNAs containing AU-rich elements (AREs) within their 3' untranslated regions, and in RNA surveillance pathways, preventing translation of aberrant mRNAs. It seems to be involved in degradation of histone mRNA. The catalytic inactive RNA exosome core complex of 9 subunits (Exo-9) is proposed to play a pivotal role in the binding and presentation of RNA for ribonucleolysis, and to serve as a scaffold for the association with catalytic subunits and accessory proteins or complexes. [UniProt]
For Research Use Only. Not for use in diagnostic procedures. Not for resale without express authorization.
Bioinformatics
Protein Aliases: Chronic myelogenous leukemia tumor antigen 28; CML28; exoribonuclease; Exosome complex component RRP46; exosome complex exonuclease RRP46; Exosome component 5; exosome component Rrp46; p12B; Ribosomal RNA-processing protein 46; unnamed protein product
Gene Aliases: CABAC; CML28; EXOSC5; hRrp46p; p12B; RRP41B; RRP46; Rrp46p
UniProt ID: (Human) Q9NQT4
Entrez Gene ID: (Human) 56915, (Rat) 308441

Performance Guarantee
If an Invitrogen™ antibody doesn't perform as described on our website or datasheet,we'll replace the product at no cost to you, or provide you with a credit for a future purchase.*
Learn more
We're here to help
Get expert recommendations for common problems or connect directly with an on staff expert for technical assistance related to applications, equipment and general product use.
Contact tech support